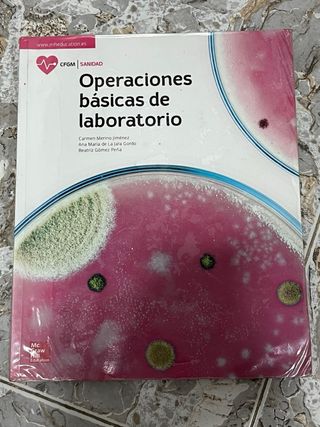
libros grado medio técnico farmacia y paraf.

Libros Grado Medio Farmacia de segunda mano
Novedades
Libro de grado medio de farmacia y parafarmacia.
Libro 5 € cada uno

Vendo libros grado medio de farmacia
Libros grado medio farmacia

Libros grado medio farmacia
Libros grado medio farmacia los 5 por 50€
Oficina de farmacia
Libro de grado medio de farmacia de oficina de farmacia
Oficina de farmàcia (CFGM FARMACIA I PARAFARMAC...
Libro grado medio de farmacia y parafarmacia de oficina de farmacia en catalán

Libro Oficina de Farmacia
Libro de grado medio de Farmacia y Parafarmacia CFGM Farmacia y Parafarmacia. Algo subrayado pero en buen estado. ESCUCHO OFERTAS
ANATOMOFISIOLOGIA Y PATOLOGIAS BASICAS. GRADO M...
Ciclo formativo grado medio farmacia y parafarmacia
Oficina de farmacia
Libro de oficina de farmacia, del grado medio de farmacia y parafarmacia, en buen estado sin subrayar ni pintado
Dispensacion de productos farmacéuticos (2.ª ed...
Está subrayado Grado medio de Técnico en farmacia y parafarmacia.
Formulación magistral
Está subrayado. Grado medio de Técnico en farmacia y parafarmacia.
Disposicion y venta de productos.Grado medio
Libro para un grado medio a mí me sirvió para el de farmacia
Oficina de farmacia
Libro de grado medio de farmacia algo subrayado
libros grado medio farmacia
libros grado medio farmacia, tengo todos los de la lista (segunda foto) + OFICINA DE FARMACIA + DISPENSACIÓN DE PRODUCTOS FARMACÉUTICOS +DISPENSACION Y VENTA DE PRODUCTOS + OPERACIONES BÁSICAS DE LABORATORIO
LOTE 4 libros, Farmacia y Parafarmacia
LOTE 4 libros, para estudiar en el primer curso de FP Grado Medio, de Farmacia y Parafarmacia. Cada uno lleva una foto donde se ve claramente su ISBN respectivo.
Libros de Farmacia grado medio.
Libro 1 ...10 euros. Nuevo Libro 2...27 euros. Nuevo Libro 3...27 euros usado, buen estado, algo escrito. Si te llevas los 3, son 50 euros el lote
Dispensación de productos farmacéuticos
Libro grado medio farmacia de dispensacion de productos farmaceuticos
Libros farmacia grado medio
Vendo libros necesarios para próximo curso de grado medio técnico auxiliar de farmacia y parafarmacia -Anatomofisiologia y patologías básicas. -Operaciones básicas de laboratorio. -Itinerario personal para la empleabilidad I 1. -Dispensación de productos para farmacéuticos. -Dispensación y venta de productos. -Oficina de farmacia. -Digitalizacion.
3 libros de farmacia grado medio.
los 3 juntos 40, separados 15 cada uno
3 libros grado medio farmacia 1°
libros de farmacia 1° obl fol y ventas

Libros Grado Medio Auxiliar Enfermería y Farmacia
Libros para el Grado Medio de Auxiliar de Enfermería y Farmacia. - Promoción de la salud y apoyo psicológico al paciente - Editorial Itamar ISBN 84-96334-22-8
Pack libros 1º de FP Farmacia grado medio
Incluye: 👉🏻Itinerario Personal para la Empleabilidad I – Editorial Paraninfo 👉🏻 Digitalización aplicada a los sectores productivos-McGraw Hill 👉🏻Promoción de la salud – Altamar 👉🏻Dispensación de productos farmacéuticos – Síntesis 👉🏻Primeros auxilios – Altamar 👉🏻Operaciones básicas de laboratorio – McGraw Hill 👉🏻Disposición y venta de productos – Altamar 👉🏻Anatomofisiologia y patología basicas- Altamar 📍 Entrega en mano en Jerez o envío por Wallapop. Se vende pack completo, algunos en condiciones aceptables y otros como nuevos
Ingles. Grado Medio. Sanidad
Libro de grado de farmacia en inglés, esta prácticamente nuevo

Empresa e iniciativa emprendedora. Grado medio/...
Vendo libro de Farmacia y Parafarmacia CFGM
Libros de grado medio1° de farmacia
Vendo 2 libros" itinerario personal para la empleabilidad I, sostenibilidad aplicada al sistema productivo, comprados nuevos el año pasado, utilizados solamente un año están forrados sin ningún roce todas las hojas perfectamente incluyo en las fotos el código de cada libro, el lote 22€, libro por separado a 15€ cada uno, precio no negociable, urge venta por traslado
Empresa e iniciativa emprendedora 4.ª edición
Libro para grado medio de farmacia o cualquier grado que realice clases de empresa

HAGO ENVIOS Oficina de farmacia
SOY RICARDO C DIEZ AÑOS EN WALLAPOP Y MAS DE 400 VALORACIONES POSITIVAS ME ELIMINARON LA CUENTA EL 19/9/24 Oficina de farmacia ISBN 9788448622435 McGraw Hill (15 abril 2021) Farmacia y parafarmacia Grado medio Hago envios
Formulación Magistral
Libro de grado medio de farmacia de formulacion magistral
Dispensación de productos parafarmacéuticos
Libro de grado medio de farmacia de dispensacion de productos parafarmaceuticos
Operaciones básicas de laboratorio
Libro de grado medio de farmacia de laboratorio
Disposicion y venta de productos Gm 22 Cf
Libro escolar grado medio de farmacia
Formulacion magistral. GM
Libro grado medio de farmacia y parafarmacia
Libros farmacia y parafarmacia
vendo libros del grado medio de farmacia y parafarmacia, tanto de primero como de segundo, venta preferible en mano en Málaga. Pregunta precio por privado sin problemas!! Libros muy cuidados, algunos casi nuevos, con pocas anotaciones.
Promoción de la salud
Lote de 2 libros de grado medio. Uno es solamente del ciclo de farmacia y el otro, el de Anatomia, es transversal a varios ciclos de grado medio de Sanidad incluído el de Farmacia. Tienen algunas actividades resueltas a lápiz que se pueden borrar. No se venden por separado.
Libro de texto Oficina de farmacia
Libro oficina de farmacia para grado medio de técnico en farmacia y parafarmacia. Sin anotaciones, ni subrayados. En perfecto estado.

HAGO ENVIOS Oficina de farmacia Altamar 2020
SOY RICARDO C DIEZ AÑOS EN WALLAPOP Y MAS DE 400 VALORACIONES POSITIVAS ME ELIMINARON LA CUENTA EL 19/9/24 Oficina de farmacia ISBN 9788417872489 Altamar 12 junio 2020 Farmacia y parafarmacia Grado medio Hago envios
Oficina de farmacia
Libro para Ciclo Formativo Grado Medio de Sanidad. Bastante usado con notables signos de desgaste pero el interior está como nuevo con algunos ejercicios en lápiz

Disposicion y venta de productos.Grado medio
Grado medio farmacia
Oficina de Farmacia
Libro de ciclo formativo grado medio de Farmacia y Parafarmacia. El libro está subrayado pero en buenas condiciones. Más libros en mi perfil.
Empresa e iniciativa emprendedora. Grado medio/...
Libro de CFGM FARMACIA Y PARAFARMACIA
Libro grado medio farmacia
promocion de la salud. Casi nuevo (lo unico que tiene es subrayado en algunas paga)
Disposicion y venta de productos.Grado medio
Farmacia

Empresa e iniciativa emprendedora. Grado medio/...
Libro farmacia grado medio
Libros de grado medio de farmacia y parafarmacia
Estan en perfecto estado. El de anatomía esta en color y el de oficina de farmacia y el de operaciones básicas de laboratorio estan los dos en blanco y negro. El precio que pongo es por los tres si se quiere alguno en concreto mas información por privado.
Libros de grado medio de farmacia
Usados pero en buen estado LOS LIBROS TACHADOS ESTAN VENDIDOS 😊 Cada libro 5€ y se compra todo 4€ por cada libro. Escucho ofertas Si se quiere por separado crearia un articulo nuevo con peso de envio mas pequeño
Lote de libros primero grado medio farmacia
Libros primero de grado medio de farmacia y parafarmacia - Oficina de farmacia - Operaciones básicas de laboratorio - Disposición y venta de productos Como nuevos, no fueron usados.
Farmacia y Parafarmacia grado medio 1° curso
5 libros de farmacia y parafarmacia grado medio 1° curso. Un año de uso. El precio es del lote completo.
Libro GM Farmacia
Libro de Empresa e Iniciativa Emprendedora de Grado Medio de 2° de Farmacia Tiene anotaciones a lápiz Está como nuevo y forrado
Formulación Magistral
Libro de Formulación Magistral de Grado Medio de farmacia y parafarmacia esta completamente nuevo por dentro a partir del tema 8 se ven pequeñas cosas el lapiz
Libro de anatomía 1° de grado medio de farmacia
9788417872007
Libro Disposición y Venta de Productos
Libro de texto sobre disposición y venta de productos. 1º de grado medio de farmacia. - Título: Disposición y venta de productos - Autores: Maite Tocino, Miquel Recasens, Sara Torralba, Mª Pilar Giménez - Editorial: Altamar - 9788418843310
libros primero farmacia
vendo libro de primero de farmacia (grado medio) totalmente nuevos menos el de disposición y ventas de productos y anatomofisiología y patología basicas (esos dos serian 15€) Itinerario personal : 978-84-1134-936-9 laboratorio: 978-84-486-4258-7 ventas: 978-84-486-2288-6 anatomia: 978-84-486-1163-7 p.auxilios:978-84-486-4230-3 digitalización:978-84-1134-930-7 promocion salud: 978-84-486-4725-4 productos para farmacéuticos: 978-84-486-4733-9
Libro sostenibilidad 2 año grado medio farmacia
Libro nuevo sin estrenar de sostenibilidad de 2 año farmacia y parafarmacia
Empresa e iniciativa emprendedora. Grado medio/...
Libro de farmacia, forrado.
Libros farmacia y parafarmacia
Conjunto de libros del primer año del ciclo formativo de grado medio de farmacia y para farmacia de ilerna
libros grado medio técnico farmacia y paraf.
libros seminuevos, en muy buen estado.
Libros Grado medio Farmacia y Parafarmacia
Libros en perfecto estado al 50% valen cada uno 30€
Libros Grado Medio de Farmacia y Parafarmacia.
Se venden los libros de Oficina de Farmacia, Dispensación de productos para parafarmacéuticos, Itinerario Personal Para la Empleabilidad I y Anatomofisologia y Patología básicas para el grado medio de Farmacia y Parafarmacia en Madrid. No se hacen envíos.